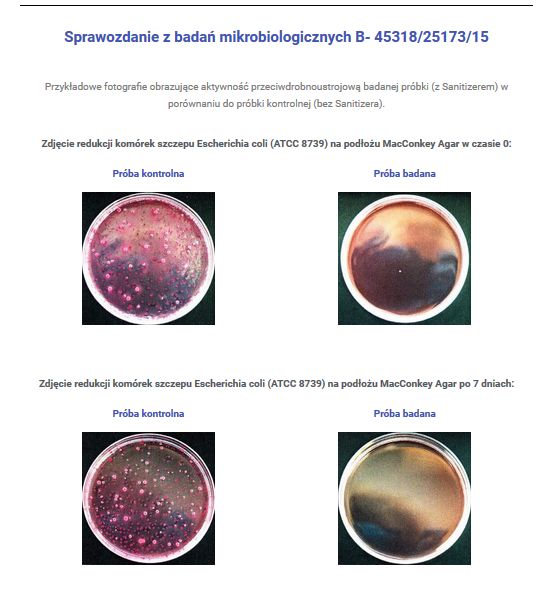

Łatwy zwrot towaru
NANO SILVER aerosol SANITIZER pojemność 500 ml
Wyprodukowano w Polsce
Działanie potwierdzone badaniami przez niezależne jednostki badawcze.
Jest to preparat z drobinkami srebra służący do dezynfekcji powierzchni, przedmiotów i materiałów, które nie mają kontaktu z żywnością. Wykazuje działanie bakteriobójcze, grzybobójcze i wirusobójcze
Do użytku domowego.
Odkażanie i dezynfekcja obuwia, akcesoriów sportowych, motorowych, rowerowych, narciarskich, kasków, rękawic, legowisk zwierząt, ścian, mebli, foteli, tkanin, zasłon, materacy, kafelek, wykładzin, dywanów, fug, toalet- wszędzie tam, gdzie istnieje zwiększone ryzyko kontaktu z mikroorganizmami. Niezastąpiony w każdym gospodarstwie domowym.
Do użytku profesjonalnego
Dezynfekcja przedmiotów, wyposażenia, powierzchni i urządzeń sanitarnych w szpitalach, przychodniach, gabinetach dentystycznych, weterynaryjnych, domach opieki, salonach tatuażu, salonach fryzjerskich i kosmetycznych, solariach, klubach fitness, gabinetach masażu, hotelach, restauracjach, pracowniach komputerowych, wypożyczalniach obuwia sportowego, butów narciarskich itp.
Jak działa srebro?
Wyjątkowe właściwości srebra znane już były w Starożytnej Grecji i Rzymie, ale w medycynie zyskało ono na znaczeniu dopiero w pierwszej połowie XX wieku. Dzięki rozwojowi nauki i świadomości społeczeństwa, surowiec ten staje coraz bardziej doceniany i powszechnie stosowany. Coraz częściej określa się je mianem “naturalnego antybiotyku”. To wszystko za sprawą jego działania przeciwbakteryjnego, przeciwgrzybiczego i przeciwwirusowego. Ważne jest to, aby jego ogólna powierzchnia była jak największa, co uzyskuje się dzięki rozdrabnianiu cząsteczek na jak najmniejsze drobinki nanosrebra. Im mniejsze drobiny srebra, tym więcej jonów srebra uwalnia się w kontakcie z tlenem i silniejsze działanie przeciwdrobnoustrojowe.
Zastosowanie

Nieprzyjemny zapach z butów? Ten problem może dotyczyć każdego z nas, nie tylko sportowców. Nasz preparat nie maskuje przykrego zapachu, lecz likwiduje jego przyczynę, czyli namnażające się bakterie i grzyby. Wystarczy spryskać wewnętrzną stronę buta, odczekać kilkanaście minut do odparowania preparatu i gotowe!

Regularne czyszczenie i pranie legowiska (nawet w wysokiej temperaturze) nie zawsze wystarcza, aby pozbyć się nieprzyjemnego zapachu i odpowiedzialnych za niego bakterii, wirusów i grzybów. Utrzymanie czystości wokół naszych pupili ma również ogromne znaczenie w zapobieganiu groźnym chorobom naszych podopiecznych. Produkt nadaje się również do dezynfekcji kuwet.

Gdy meble zbyt długo znajdują się w zawilgoconych pomieszczeniach, mogą zacząć wydzielać nieprzyjemny zapach. Domowymi sposobami trudno jest się pozbyć zapachu stęchlizny, a oddanie kanapy do profesjonalnego czyszczenia może sporo kosztować. Nanosrebro znane jest ze swoich właściwości dezodoryzujących, likwiduje przykry zapach stęchlizny i pozwoli Ci cieszyć się przyjaznym otoczeniem na długi czas.

Łatwość, z jaką przy użyciu naszego preparatu można dezynfekować materace docenią nie tylko właściciele hoteli, pensjonatów, pracownicy szpitali, ale również każda gospodyni domowa. Gwarancją prawidłowego wyczyszczenia i zdezynfekowania materaca jest jego dokładne wysuszenie, co w przypadku większości materacy jest praktycznie niemożliwe. Nasz produkt odparowuje ze spryskanej powierzchni już po kilkunastu minutach!

Zalanie piwnicy, nieszczelny dach, nieodpowiednia cyrkulacja powietrza lub po prostu zbyt wysoka wilgotność mogą sprawić, że na ścianach pojawią się nieproszeni “goście”: pleśń i grzyby. Podstawą jest eliminacja przyczyny problemu, ze skutkami pomogą rozprawić się nanocząstki srebra, które skutecznie pozwolą Ci uporać się z zagrzybiałymi ścianami.

Nie tylko toalety publiczne to skupiska chorobotwórczych bakterii i wirusów. Dla bezpieczeństwa Twoich najbliższych, pamiętaj o regularnej dezynfekcji muszli klozetowej, wanny, baterii łazienkowej, pojemników na odpadki higieniczne i innych urządzeń sanitarnych w Twojej łazience. Dlaczego? Ograniczysz w ten sposób rozprzestrzenianie się tzw. “chmury bakteryjnej”, która z każdym spłukaniem wody rozsiewa się nawet na odległość 2m.
Utrzymanie w czystości kasku, rękawic i pozostałych akcesoriów motorowych i rowerowych to podstawa. Niestety, nie we wszystkich kaskach można zdemontować wyściółkę wewnętrzną i ją wyczyścić, tak więc utrzymanie higieny w tym wypadku to nie lada wyzwanie. Używając preparatu do dezynfekcji NANO SILVER aerosol SANITIZER zlikwidujesz bakterie rozkładające pot i usuniesz przykry zapach.
Ośrodki jeździeckie, wypożyczalnie sprzętu narciarskiego i snowboardowego doskonale wiedzą, jak ważne jest bezpieczeństwo ich klientów i zagwarantowanie im czystego i zdezynfekowanego sprzętu. W normalnych warunkach dezynfekcja takiego sprzętu jest droga i bardzo czasochłonna, z NANO SILVER aerosol SANITIZER cały proces trwa kilka minut. Działanie baketrio, wiruso i grzybobójcze zostało potwierdzone badaniami. Nie ma nic przyjemnego w zakładaniu śmierdzącego i przepoconego toczka w upalny dzień, prawda?
Dbanie o czystość i higienę każdego salonu piękności i gabinetu masażu to podstawa. Ważne jest zarówno dbanie o narzędzia, jak i o fotele, oparcia, blaty. Codziennie odwiedzają je dziesiątki klientów, dlatego żeby zapewnić bezpieczeństwo sobie, pracownikom i pozostałym klientom, zapobiegać rozprzestrzenianiu się groźnych patogenów, warto pomyśleć o długotrwałej ochronie. Biobójcze działanie NANO SILVER aerosol SANITIZER zostało potwierdzone niezależnymi badaniami.

NANO SILVER aerosol SANITIZER świetnie sprawdzi się także w gabinetach stomatologicznych, przychodniach, lecznicach weterynaryjnych, domach opieki. W kilka minut będziesz w stanie zdezynfekować wszystkie powierzchnie w swoim gabinecie, aby zapewnić wolne od mikroorganizmów otoczenie sobie i innym.

Dzięki poręcznemu opakowaniu oraz szybkiej i łatwej aplikacji, produkt nadaje się do użytku profesjonalnego i domowego. Korzystny stosunek jakości do ceny, wydajność i długotrwałe działanie potwierdzone badaniami sprawiają, że jest to produkt niezbędny w każdym domu i w każdym zakładzie użyteczności publicznej. Znajduje zastosowanie także w salonach tatuażu, solariach, hotelach, pracowniach komputerowych, klubach fitness, wypożyczalniach samochodowych i wielu innych. Teraz osiągnięcia nanotechnologii są na wyciągnięcie ręki!

Preparat NANO SILVER aerosol SANITIZER został rygorystycznie przebadany pod kątem skuteczności działania (bakterio, grzybo i wirusobójczego) oraz jego bezpieczeństwa stosowania. Właściwości produktu zostały udokumentowane niezależnymi badaniami.

| SYMBOL TOWARU: | NANO |
| POJEMNOŚĆ: | do wyboru 125 ml lub 500 ml |
| ILOŚĆ: | 1 |
| Parametr bezpieczeństwa: | Tak |



